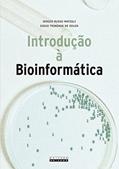
Ler Introdução à bioinformática, do autor Diego Trindade de Souza Ler Introdução à bioinformática, do autor Diego Trindade de Souza

A Introdução à bioinformática, de Diego Trindade de Souza, não é apenas uma obra técnica; é uma porta aberta para um mundo fascinante onde a biologia se encontra com a computação, revelando uma sinfonia de dados que transformam a forma como compreendemos a vida. Este livro, que esbanja conhecimento e curiosidade científica, te convence a mergulhar nas profundezas de uma área que promete revolucionar não apenas a pesquisa científica, mas também a medicina, a genética e até a agricultura! 🌱💻
Quando você se debruça sobre as páginas escritas com primor por Souza, percebe a paixão e o compromisso do autor em desmistificar um campo tão complexo e, por muitas vezes, intimidante. Seja você um estudante em busca de conhecimento, um profissional que deseja expandir seus horizontes ou até mesmo um curioso sedento por saber mais sobre o que está por trás da biologia molecular, este livro é o seu guia!
Ao longo das suas 176 páginas, o autor explora conceitos fundamentais, algoritmos e ferramentas que fazem da bioinformática uma área de tantas possibilidades. Você não pode deixar de sentir a eletricidade no ar enquanto decifra como o sequenciamento genético, a análise de proteínas e a modelagem de doenças interagem em uma dança intricada que pode gerar descobertas impactantes. E mais, a forma como Souza conecta esses tópicos com exemplos práticos e atuais faz você se sentir como um verdadeiro detetive da biologia, investigando os mistérios da vida com a precisão de um cientista. 🧬🔍
Mas não para por aí. As opiniões dos leitores revelam uma diversidade de reações a essa obra. Muitos exaltam a clareza e a didática do autor, que soube traduzir informações densas em uma linguagem acessível e envolvente. Por outro lado, há quem sinta falta de uma abordagem ainda mais aprofundada em temas como as aplicações práticas da bioinformática no dia a dia da pesquisa e da saúde. Essas críticas são válidas e revelam a necessidade incessante de atualização e inovação em um campo que está em rápida evolução. ⚗️✨️
Souza, com seu background acadêmico e experiência no tema, se destaca como um farol no obscuro oceano da ciência genômica. Você sente a urgência de se inteirar sobre os avanços proporcionados pela bioinformática, especialmente em um mundo tão conturbado como o atual, onde as pandemias e crises alimentares clamam por soluções inovadoras. Assim, a leitura deste livro não é apenas uma escolha; é quase uma responsabilidade de quem deseja compreender a complexidade da vida em um nível mais profundo.
Enquanto o universo da bioinformática continua a se expandir, a obra de Diego Trindade de Souza se consolida como uma base sólida para todos aqueles que desejam embarcar nessa jornada. Não adianta esperar que o conhecimento caia do céu; ele é construído, palavra por palavra, descoberta por descoberta, e Introdução à bioinformática é uma peça fundamental nesse quebra-cabeça. ⚡️🔬
Não fique fora dessa! Aprenda, questione e avance para além das fronteiras do tradicional. Essa leitura revela não apenas o quanto temos a descobrir sobre nós mesmos, mas também o quanto a ciência pode fazer por nós no futuro. Vá em frente e mergulhe de cabeça; a bioinformática está clamando por você!
📖 Introdução à bioinformática
✍ by Diego Trindade de Souza
🧾 176 páginas
2021
#introducao #bioinformatica #diego #trindade #souza #DiegoTrindadedeSouza